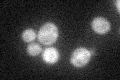
YHR077C
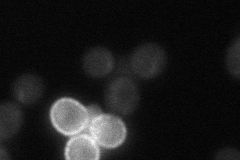
YHR077C

View description
Protein involved in the nonsense-mediated mRNA decay (NMD) pathway; interacts with Nam7p and Upf3p; involved in telomere maintenance
Localization:
Intensity:
Fold change:
Significance:
-
C’ GFP library in SD
cytosol30.11 -
N' NOP1pr-GFP in SD

cytosol51.0139 -
N' TEF2pr-mCherry in SD

cytosol55.9091 -
N' NATIVEpr-GFP in SD
cytosol28.3147 -
N' TEF2pr-VC and Cyto-VN in SD

cytosol39.5397 -
C’ GFP library in SD+DTT

cytosol27.980.92No -
C’ GFP library in SD+H2O2

cytosol32.971.09No -
C’ GFP library in Starvation Media

cytosol23.380.77No -
C’ GFP library on the background of Pup2-DaMP

N/A -
C’ GFP library on the background of CCT mutant

N/A0N/AYes
